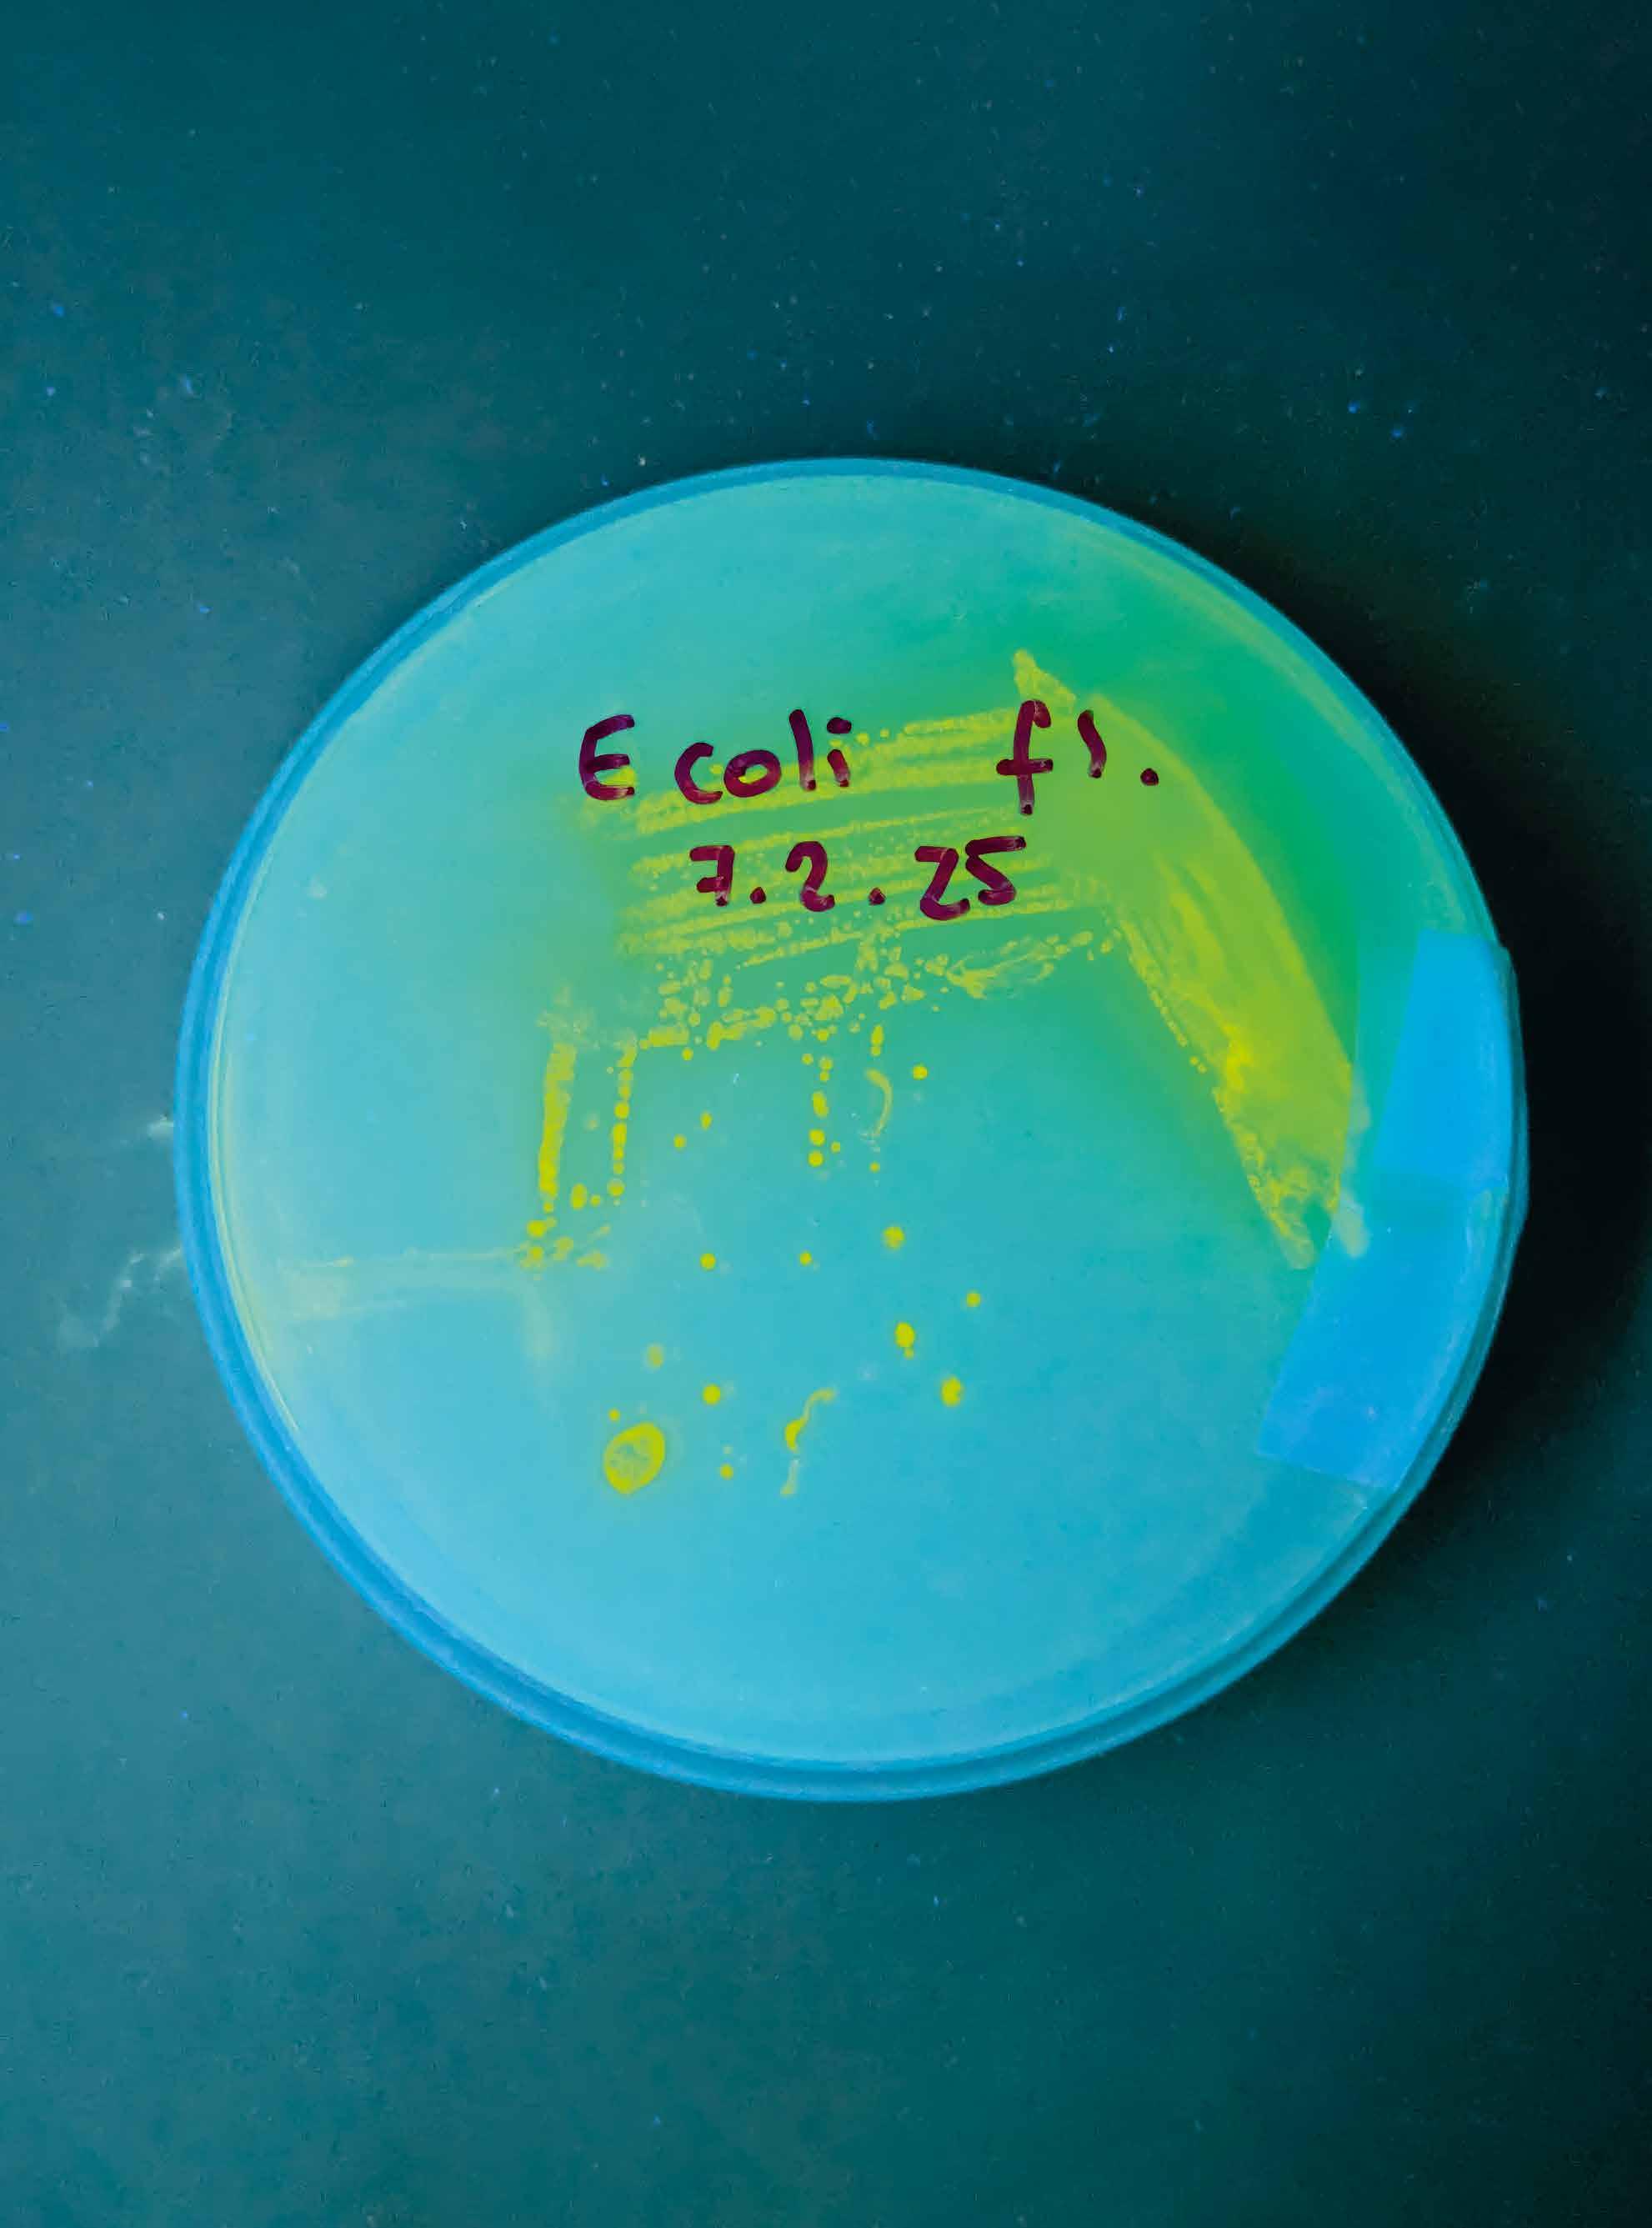

Logar (ed.)
![]()

Logar (ed.)


Karez
Herwig
—03/01.03
Herwig Steiner
—03/01.04
Andrei Molodkin
—03/02
Alejandra Rodríguez-Remedi
—03/02.01
Pit Arnold
—03/02.02
From Oil Encounters to Oil Reflections
Jordan B. Kinder
—03/02.03
—03/02.05
Raw and the Refined
Benjamin Steininger
—03/02.06
Arianna Mondin
—03/03
Olaf Osten Ulrike Payerhofer

Raphaelle Occhietti
Simone Gingrich
—03/02.04
David Misch
Ernst Logar
As our contemporary society slowly shifts away from fossil fuels as an energy source, there is still an urgent need to reduce CO2 emissions, which are contributing to global warming and climate change. In order to better achieve the transition towards sustainable energy sources, it is essential to understand how energy sources shape a society and its culture. Even though modern life is primarily built upon an omnipresent culture of oil (petroculture) and the resource’s wide range of applications and uses, there is very little public knowledge or awareness about it.
The interdisciplinary artistic research project Reflecting Oil: Arts-Based Research on Oil Transitionings (2019–2024) sheds light on this important topic and offers an innovative and multiperspectival reflection on crude oil. It approaches the substance from a holistic perspective, giving rise to new representations and narratives about oil that should bring about a radical change in public perception and new visions of a sustainable future without oil.
To give readers an overview of the book’s content right from the start, I would like to briefly guide you through the various chapters. This publication captures the artistic research project in all its facets, organized into four chapters that correspond with the structure of the project and its research formats and methodologies.
After the preface by Alexander Damianisch and his introduction to the concept of “cognitive resonance,” Chapter 1 consists of introductory statements by the three cooperation partners. My essay as the project leader outlines the basic ideas of the research process; Holger Ott, as our domestic cooperation partner (Department Geoenergy, Montanuniversität Leoben, Austria1), presents the project from the perspective of a petroleum engineer; and the text by Imre Szeman, our international research partner (Petrocultures Research Group, University of Alberta, Canada), looks at petroculture and crude oil against the backdrop of the term “experiment.”
The second chapter features an exemplary selection of artistic crude oil experiments based on innovative approaches to the perception of the substance, whose findings provide new knowledge and creative incentives for future investigations.
The Reflecting Oil Colloquium, held at the University of Applied Arts Vienna from June 9 to 12, 2022, is documented in Chapter 3: the book structure follows the workshop formats of the three working groups. Working group 1 takes an experimental approach to crude oil in the chemistry laboratory; group 2 deals with the
in/visibility of the substance on the levels of image and text; group 3, in turn, speculates about a potential transformation process towards the post-fossil age in the form of a graphic novel. The sequence of the colloquium contributions is aligned with their thematic focus, spanning from the geological formation of crude oil to its actual visibility and geopolitical impacts.
The fourth and final chapter is dedicated to my artistic works inspired by the experiences and knowledge obtained in the overall interdisciplinary research process, which were presented as part of the exhibition Reflecting Oil—Petroculture in Transformation at the Angewandte Interdisciplinary Lab (AIL) from October 2 to November 15, 2024. My works and the contributions by participants of the Reflecting Oil Colloquium are documented, reflected upon, and contextualized by art historian Raphaelle Occhietti.
This book features a broad spectrum of perspectives on and perceptions of crude oil, which overlap, intersect, and refer to one another in their contents. To reveal these connections, a system of keywords has been integrated into the layout, exhibiting the interdisciplinary and collaborative nature of the research process and the true complexity of this subject.
Hoping that this project and publication can contribute to a much needed step in the transition towards a sustainable future, I wish you an inspiring and insightful read.
1 In the book, Montanuniversität Leoben is referred to as the University of Leoben. In 2024, the Department Petroleum Engineering was renamed the Department Geoenergy.
Alexander Damianisch
First let me introduce the concept of cognitive resonance,1 it is about understanding that emerges when incompatibilities are reconciled, and my belief is, that artistic research is an important key practice for its fruition—and the Reflecting Oil project is an outstanding example.
Indeed, in our imaginations, it was once possible to turn water into wine and iron into gold, and to even turn research into art and art into research, with the welcome fact that the latter metamorphosis actually works. It is always interesting to ask how such a material and conceptual transformation manifests concretely, and what remains, with a dash of fantasy, of the so-called trans-substantive hope? One example is Ernst Logar’s artistic research, which epitomizes such a capacity for change, its deployment and critique. He and his team have succeeded by emphatically directing our attention to a very specific and extremely bitter substance: crude oil.
Artistic research is framed here as a modern variant of alchemy, and new materialism also comes into play, whereby art is tuned, as it were, as a vessel for the intangible and as an instrument for the elusive with no small responsibility and potential. In the history of science and epistemology, both are original and valid, and both resonate vibrantly in Reflecting Oil. It is wonderful that Ernst Logar and his team come quite close to us in their joint research—and this is precisely where the special appeal of the project lies. It is their approach to the found material, but also how they handle the very artistic results. The project space is at once a studio and a laboratory, working on reality, models, and ideas, alternative perspectives and idiosyncrasies. These are results unfolding within each individual dedicated to this and similar research. Once more, it is the viewers who are transformed; in this sense, too, this research comes very close, confronting us with its relevance: the project demonstrates that thinking oil can be turned into gold is a short-sighted misconception. When some believed this to be the case, things went wrong—especially when organic material once alive simply goes up in smoke, burns away. Many a dream shattered in its fulfillment. This is what we are currently experiencing, sinking deeper and deeper into the mess; what remains is evidence of failure and our fundamental responsibility.
“The materiality of oil as a substance,” reads the project description, “is the basis of our research project Reflecting Oil,” which investigates “the role of oil in geopolitical conflicts, as a cause of environmental pollution, and also as a socio-cultural
object of desire,” making it visible in a new way. This formulation alone encapsulates the tangents between the dirty, the raw, and the dangers of what is valuable to us. Should we speak of the danger of valuable things or of the value of danger, or even both? How was it again with water and wine, iron and gold? How can it be continued with oil...?
This book is a new attempt to explore such relationships with the means of art and to unearth perspectives that have gone undiscovered until now. Once again, art transforms the everyday—iron, water, stone, or in this case, oil—and helps us to see the unexpected in a way that no one has ever seen before, scrutinizing our perception.
Sustainability entails envisioning and cultivating what is essential, and then being prepared to give up what once seemed possible but was not really essential. Reflecting Oil teaches us anew that we are well advised to not only feel but also perceive and reflect with all our senses. To allow the connections to come close, to grasp them in a cognitively resonant way. It is not enough to simply say “hindsight is always wiser.” It is crucial to recognize that being wise also means, as Ernst Logar and his team do, to enthusiastically and ingeniously wrest new aspects from the dirt that previously went unrecognized. Perhaps this also gives rise to something like hope—we will read about it. Because, as we all know, hope dies last... Let’s embrace our responsibility, and this research is an excellent source of inspiration.
In short: let’s start taking our cognitive resonance seriously.
1 Cognitive resonance refers to the dynamic process of the continuously evolving combination of perception, understanding, reflection, and creation in a constant state of critical openness and transformation towards an interest (object) as well as the interest (subject) itself.
Holger Ott
experiments
petroleum engineering
crude oil
Hele-Shaw cell tipping point pore space distillation petro-objectivity energy transition
The climate crisis causes society to rethink. We are questioning our lifestyles and energy consumption. We are aware—at least in part—of the consequences of our actions and our climate targets are becoming more ambitious. But despite all these good intentions, our climate footprint is, unfortunately, not changing, or only insufficiently, and we are unable to reduce our dependence on fossil resources—why is that? Perhaps we need to start with an analysis.
Technology: Technologies to help with the energy transition are constantly being developed and refined. Technical prerequisites are necessary to achieve the energy and climate transition, but alone they are not sufficient. We have enough mature technologies at hand for a rethink and to switch to a sustainable energy supply, so this is not about our technological maturity, it is about our maturity as a society. The question we need to ask ourselves is: how long will it take to rebuild our existing infrastructure into something capable of supplying society with enough energy and all kinds of goods, while also maintaining our prosperity and protecting the climate? In other words, what is required for such a reorganization? Or, is the transformation of our “energy-hungry” society into a sustainable version of itself realistic? Probably not!
Attempting to deal with the substance of oil is important because, despite all our efforts to reduce our dependency on them, fossil fuels will likely remain with us for some time to come.1 Social change is slow for many reasons, including a lack of available alternatives, raw materials, investment funds, labor, etc. All socio-economic energy and climate scenarios point in the same direction.2 Consequently, this means that not only must we move away from fossil fuels, we must also learn to deal with them and their proxy—crude oil. And this involves rethinking many aspects of our lives, from increasing energy efficiency to controlling emissions and reviewing our high-energy lifestyles.
Figure 1
Hele-Shaw experiment where crude oil is displaced by milk. The complex pattern is a result of instable displacement.

Imre
There have been all manner of experiments conducted on and in relation to oil. Yet the level of ongoing technological innovation and invention required to drag the stuff out of the ground is still not readily apparent. In the broad cultural imaginary, oil comes gushing from the earth when old-hat local know-how is combined with the brute muscular energy of roughnecks—the stuff of nineteenth-century blackand-white photos or Hollywood films like The Treasure of the Sierra Madre (1948), Giant (1956), or There Will Be Blood (2007).1 This vision of oil’s origin—as marked by bodily toil and cries of “Eureka!”—has been as effective in moving it out of sight and out of mind as has the complex technological network that transmutes liquid into something without substance: energy. After all, what could the muck and grease accumulating in the soil below oil derricks possibly have to do with the energy that appears from neat white sockets located conveniently in walls and gives life to the shiny computers plugged into them? If there have been oil experiments, we believe they are—they must be—a thing of the past. Technology has moved on, and so, too, has the energy which brings it to life.
The reality of things is of course quite different. Oil remains essential to the daily operations of contemporary life, despite the planetwide growth in renewable energy, and continues to be a way for wealthy companies and countries to retain and further expand their wealth. The ever-growing difficulty of accessing fossil fuels has necessitated endless mechanical and scientific experimentation to keep it flowing at current levels of demand—over 102 million barrels per day.2 After a century and a half of petromodernity, producers have been forced to hunt for oil in more and more remote locales. Giant sea-bound oil derricks housing hundreds of workers can be found off the coastlines of almost every continent. In the Arctic tundra, oil flows out of drill sites made possible by advanced equipment designed to withstand the extreme cold. Fracking, a process of injecting a sophisticated chemical stew into the ground at high pressures, has been invented to free natural gas from shale rock. Perhaps the most significant of all these experiments is the extraordinary system of pipelines encircling the planet, moving petroleum and gas across rivers, plains, and mountains to markets, where another transmutation takes place—not liquid into energy, but black into gold.

These contemporary experiments, deliberately hidden from view and increasingly difficult to visualize, have become a key element of the enormous technocratic apparatus that sustains modern existence—a global, material system most of us neither fully understand nor want to know about. As ever, the rule of the modern citizen-subject in the Global North holds true: out of sight, out of mind, especially when it comes to the traumas being daily inflicted on the planet 3
The necessity of experimenting with oil is especially evident in the vast landscape of the Alberta oil sands. The challenge of freeing usable oil from the sand to which it is bound has led to radical and extreme technological experiments. The systems of trucks and conveyors used in the oil sands are of an unimaginable scale; the pipes and towers of the processing facilities are not far behind. It has been argued that, taken as a whole, the oil sands constitute the largest capital project on the planet at present—indeed, perhaps of all time, having already consumed US $200 billion on an extraction site the size of Florida. The sheer cost of surface mining— the process still being used in the oil sands—has necessitated that companies experiment with new ways to get at the precious black stuff, such as steam assisted gravity drainage (SAGD), or the invention of new, increasingly toxic chemical solvents to separate sand from oil. The physical space of the oil sands is viscous and dirty, a canyon of extraction as deep as any ever cut into the earth by human beings. The oil produced in Alberta is made, enabled, and kept alive by satellites and computers, with AI-assisted oil extraction likely just around the corner.
These are only the most recent experiments on the oil sands. In the 1950s, geologist Manley Naitland invented a way of getting oil from the sands that, he hoped, would have allowed companies to sidestep the need for big machinery


Michael Duchêne
Bacteria are the most ancient form of life on Earth, for which fossil records (called stromatoliths) of more than three billion years old exist. Due to their small size, they were discovered only around 350 years ago, and Antoni van Leeuwenhoek is credited for this scientific breakthrough. In 1882, Robert Koch discovered the mycobacteria as a cause of tuberculosis. In recent years, it has become clear that the human body is an open ecosystem containing many different bacteria in almost all tissues, with the largest numbers found in the colon (large intestine).1 Taken together, the number of bacteria is comparable to the total number of cells in the human body.2 The bacteria do not only help to digest the food we eat, but they also provide nutrients and vitamins to the cells in our large intestine. Escherichia coli bacteria (Figure 1) are found in the human intestine, so if they are found in water samples, this is a sign of fecal contamination. On the other hand, E. coli is the old workhorse for biochemistry and genetics. Here we describe the interaction of living E. coli bacteria with crude oil samples, a non-living material derived from ancient life.
Interaction of Bacteria with a Crude Oil Sample
Crude oil is a mixture of hundreds of components in widely different concentrations.3

How can we find out if some components are toxic to normal bacteria like E. coli?
In an altogether different field, extracts from Stemona collinsae, an Asian plant, were investigated for their toxic activity against the common fungus Cladosporium herbarum.4 Plant extracts were separated by thin layer chromatography (TLC) and the fungal spores were directly sprayed onto the TLC plate. Areas of reduced fungal growth were tested for toxic components of the plant extract.
Abdulhameed, Mari Fraga
Mari Fraga: We meet at the laboratory. I am from Brazil, you are from Iraq. I am an artist, you are an oil engineer. We are both women who come from countries with complex histories. In Brazil, centuries of colonialism, centuries of the capture and slavery of black people, centuries of Indigenous genocide and decades of violent dictatorship are historical wounds that are still open and bleeding. Our past is alive in the present. Our land is our body, and the body doesn’t forget trauma—the pain always returns, re-incarnates; the plot constantly re-enacts itself, in spite of our individual or collective will. At the same time, resistance is also always alive, embodied in cultural manifestations that are full of music, color, dance, and joy.
Karez Abdulhameed: The historical complexity of Iraq is rooted in its long, rich, and diverse history where successive empires, dynasties, and cultural influences marked its legacy of conflict and resilience. A sinuous history of prosperity and rapaciousness due to its resources and geographical location. Crude oil, as an ancient commodity, played a significant role in Iraq‘s modern history and shaped its economy, and its political and international interactions. Today, the world‘s thirst for more energy has grown to a scary level and has created confusion for how the world operates.
We experiment with oil, but I can‘t stop thinking about the layers of violence that are inseparable from the substance. For me, oil means energy and hopes of development, but also coups, corruption, cruel geopolitical power dynamics, and disappointment. The exploitation of natural resources is analogous to the exploitation of vulnerable bodies.
I‘ve feared and detested this natural resource all my childhood and teenage years. I viewed crude oil as a curse rather than a grace. It brought dictatorship and isolated my country from the rest of the world for the longest time. We grew far from modern societies. I didn‘t choose to study petroleum, it chose me. Back then, I was fascinated by the science and technology of oil, by its vital side, and the fact of it driving our civilization forward. I want to share the importance of understanding the value of this commodity both as an ambitious engineer and as an optimistic individual. Engineering happens to be my destiny, as now I am able to change what I once viewed as a beast.
Inside the lab, we experiment with oil, water, and salt. One of the largest reserves of crude oil found in Brazil sits at the bottom of a deep underwater salt layer. The

David Misch
The Niger Delta. An art piece of nature that, with its anastomosing riverbeds embedded into a bright green landscape prograding into the blue of the Atlantic Ocean, has an almost surreal beauty. On the other hand, as portrayed by photographer George Osodi under life-threatening conditions, an ecological catastrophe so gigantic and overwhelming that even the incorruptible camera lens seems hardly able to convey a dirty truth that words would not do justice. Millions of liters of oil spilled virtually everywhere. Almost as if an expanding black hole would suck the color out of each and every tree branch, stream, pebble, and grass root to feed its never-ending appetite. It’s not that the oil’s deep black coloration and silky shine wouldn’t also inherit a certain beauty in themselves. But disconnecting its visual elegance—for lack of a better description of its intense visual presence—from the drastic consequences of its harmful appearance, is unthinkable. Adding animals to the picture—even humans, toddlers, elderly women baking traditional bread and cake over gas flares set up a long time ago by global players in the oil industry, young, apparently strong and healthy men working in rudimentary refineries and following the promise of long-desired wealth and social status—makes for the plot of a disaster movie way beyond Hollywoodesque exaggeration. And yet the pictures show nothing but the plain reality of a society addicted to turbo consumption. A reality in which we all play our part. A reality that seldomly becomes as graphically visible as in the Niger Delta, yet existing in similar ways all over the globe— besides the realms of those wealthy enough not to be held responsible for their

actions. Could anybody look at these sceneries and not be embarrassed about the destructive power of industrialization—or whom- or whatever to blame?
The fluvial delta owes its name to the eponymous triangular-shaped Greek letter— an obvious geometric match when looking at the Nile Delta, which was first named accordingly. However, in technical language, the delta operator also means change. First introduced by the Swiss mathematician, physician, and astronomer Leonhard Euler,1 the meaning of delta as a measure of property variations—for example a differential in temperature or pressure—is now one of the first things to be brainwashed into the heads of aspiring youngsters in technical universities. Delta means change. Full stop. Did Euler, who also had a profound interest in geography, see the less obvious connection between the delta operator and the fluvial delta—both being associated with constant change?
The not so simple truth about geographical deltas is that, by far, many of them do not actually resemble the Greek letter’s



